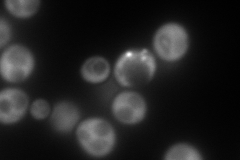
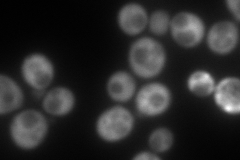
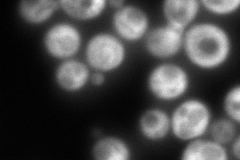
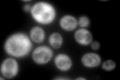

View description
Translation initiation factor eIF4A, identical to Tif1p; DEA(D/H)-box RNA helicase that couples ATPase activity to RNA binding and unwinding; forms a dumbbell structure of two compact domains connected by a linker; interacts with eIF4G
Localization:
Intensity:
Fold change:
Significance:
-
C’ GFP library in SD

cytosol622.63 -
N' NOP1pr-GFP in SD
cytosol429.557 -
N' TEF2pr-mCherry in SD
cytosol292.957 -
N' NATIVEpr-GFP in SD
cytosol365.868 -
N' TEF2pr-VC and Cyto-VN in SD

#N/A0 -
C’ GFP library in SD+DTT

cytosol741.231.19No -
C’ GFP library in SD+H2O2

cytosol637.961.02No -
C’ GFP library in Starvation Media
cytosol822.31.32No -
C’ GFP library on the background of Pup2-DaMP

cytosol -
C’ GFP library on the background of CCT mutant

cytosol668.1461.07308No
